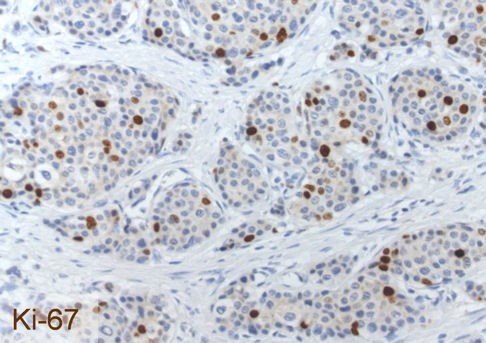

Labordiagnostik
Pathologische Diagnostik
Die pathologische Diagnostik spielt bei neuroendokrinen Tumoren (NET) eine entscheidende Rolle. Sie wird im Institut für Pathologie gemäß den Vorgaben der WHO und der ENETS durchgeführt. Das Institut für Pathologie des UKGM, Standort Marburg, ist in sechs Organtumorzentren eingebunden und verfügt über langjährige Expertise auf dem Gebiet der NET. Zu den vorgehaltenen Methoden gehören konventionelle Histologie und Zytologie, intraoperative Schnellschnittdiagnostik, Immunhistochemie (> 10.000 immunhistochemische Färbungen pro Jahr an drei Immunfärbeautomaten) mit Einsatz aller gängigen neuroendokrinen Marker, Molekularpathologie und Elektronenmikroskopie.
Jeder NET wird routinemäßig auf die neuroendokrinen Basismarker Chromogranin A und Synaptophysin sowie auf den Proliferationsmarker Ki-67 immunhistochemisch untersucht. Die Abbildungen zeigen einen gut differenzierten NET G2 des Ileums mit der typischen Histologie (HE = mikroskopisches Bild in Hämatoxylin-Eosin-Färbung), einer kräftigen zytoplasmatischen Färbung der Tumorzellen für Chromogranin A und einer Markierung von 12% der Tumorzellkerne für Ki-67. Der Nachweis von Chromogranin A und/oder Synaptophysin beweist das Vorliegen eines NET. Der Proliferationsmarker Ki-67 ist Grundlage für das Tumorgrading und von herausragender prognostischer Bedeutung. Deswegen muss der Pathologe dem Kliniker diesen Parameter zur weiteren Therapieplanung zur Verfügung stellen.
Die Befundung von NET umfasst routinemäßig die Tumortypisierung (ggf. unter Hinzuziehung weiterer immunhistochemischer Färbungen auf Peptidhormone, biogene Amine, Somatostatin-Rezeptoren), die Bestimmung weiterer Marker zur Klärung des Primärtumorsitzes bei unbekanntem Primärtumor (z.B. TTF1, CDX2), das Tumorgrading (G1 - G3) und an Operationspräparaten das Tumorstaging (TNM-System gemäß UICC/ENETS).
Biopsiebefunde sind in der Regel am Folgetag, Befunde von Operationspräparaten zwei Tage nach Eingang fertiggestellt, die Immunhistochemie (Nachbefund) einen Tag später. Im Rahmen der Qualitätskontrolle beteiligt sich das Institut regelmäßig an Ringversuchen. Unter dem Dach der Biomaterialbank des Anneliese-Pohl-CCC werden tiefgefrorene Tumorproben für Forschungszwecke vorgehalten.
Laborwerte in Form von Blut- oder Urinuntersuchungen werden bei Patienten mit Neuroendokrinen Neoplasien mit verschiedenen Zielsetzungen eingesetzt:
Bestätigung der Diagnose, Verlaufsparameter, Feststellung von Begleiterkrankungen, die bei der Auswahl der Therapie eine Rolle spielen ( z.B. Niereninsuffizienz), Überwachung von Therapienebenwirkungen ( z. B. Blutbildveränderungen), Prognoseabschätzung.
Bei den sogenannten Tumormarkern bei NEN kann man zwischen generellen Markern, die bei den meisten Patienten erhöht sind, und spezifischen Markern, die z.B. ein spezifisches Hormonsyndrom nachweisen, unterscheiden.
Der wichtigste generelle Tumormarker bei NEN ist Chromogranin A. Dieser Marker ist bei Patienten mit Hormon-Syndromen, aber auch bei Patienten mit funktionell inaktiven Tumoren häufig erhöht und kann dann als Verlaufsparameter genutzt werden. Extrem hohe Werte spiegeln eine hohe Tumorlast und damit eine ungünstigere Prognose wider. Bei der Bestimmung sollte stets dieselbe Nachweismethode Verwendung finden, da die Werte bei Verwendung verschiedener Assays unterschiedlich ausfallen können und nicht vergleichbar sind. Zudem sind andere Fehlermöglichkeiten ( z.B. erhöhte Werte bei chronisch-atrophischer Gastritis, bei Einnahme von Magensäureblockern, usw.) zu beachten.
Auch die Neuronen Spezifische Enolase (NSE) ist ein genereller Serummarker bei NEN, wobei die Bestimmung überwiegend bei den schlecht differenzierten Neuroendokrinen Karzinomen, bei denen Chromogranin A häufiger negativ ist, sinnvoll ist.
Ein weiterer genereller Marker, der bei ca. 80% der Patienten mit NEN der Bauchspeicheldrüse und ca. 50% der Patienten mit Dünndarm-NEN erhöht ist, ist das Pankreatische Polypeptid. Da es bei vielen anderen Erkrankungen ( z.B. Durchfall anderer Ursache) erhöht sein kann, wird es vorzugsweise dann als Verlaufsparameter eingesetzt, wenn Chromogranin A nicht erhöht ist.
Die wichtigsten spezifischen Marker, die ein bestimmtes Hormon-Syndrom nachweisen, finden bei der Erläuterung der Syndrome bereits Erwähnung und seien hier nur kurz zusammengefasst:
Serotonin ist das Leithormon des Karzinoid-Syndromes. Bei V.a. Karzinoid-Syndrom ist die Bestimmung des Abbauproduktes von Serotonin, die 5-Hydroxy-Indol-Essigsäure (5-HIES), im angesäuerten 24 -Stunden- Sammelurin sinnvoll.
(Pro-)Insulin und C-Peptid sind die Markerhormone des Insulinoms. Sie werden zum Nachweis ( bzw. Ausschluss) eines Insulinomes zusammen mit dem Blutzuckerspiegel im Rahmen eines sogenannten Hungerversuches engmaschig bestimmt.
Gastrin ist das Leithormon des Gastrinom-Syndromes oder Zollinger-Ellison-Syndromes. Ist der Serumnüchternspiegel nur leicht erhöht (<1000pg/ml) ist die Durchführung eines Sektretin-Testes notwendig. Hier gilt ein Anstieg des Gastrinwertes von mind. 200pg/ml nach Gabe von Sekretin als diagnostische Sicherung.
Die Bestimmung von Plasma-Glukagon ist zur Sicherung des seltenen Glukagonom-Syndromes sinnvoll, die Bestimmung von Vasoaktivem Intestinalen Polypeptid (VIP) bei Verdacht auf Vorliegen eines VIPom-Syndromes oder Verner-Morrison-Syndromes.
Zusammenfassend ist sinnvolle Labordiagnostik also von der spezifischen Situation des Patienten abhängig. Als typische Tumormarker werden in der Regel das Chromogranin A als genereller Marker und ggf. das spez. Markerhormon bestimmt.
Endoskopie:
In unserer modernen interdisziplinären Endoskopie bieten wir das komplette Spektrum endoskopischer Diagnostik des Magen- Darm - Traktes an (Gastroskopie, Coloskopie, Endosonographie, Kapselendoskopie, push- und pull Enteroskopie des Dünndarms, ERCP).
Zur endoskopischen Ultraschalldagnostik incl. Punktionen stehen moderne leistungsfähige Endosonographiegeräte zur Verfügung.
Nuklearmedizinisches Verfahren in der Diagnostik neuroendokriner Neoplasien
Neuroendokrine Neoplasien (NEN) zeichnen sich neben anderen, teils sehr speziellen Eigenschaften, durch das häufige Vorhandensein des sogenannten Somatostatin-Rezeptors aus. Dieser an der Zelloberfläche anzutreffende Rezeptor ist Vorraussetzung zur Durchführung der Somatostatin-Rezeptor-Szintigraphie (SRS). Seit Mitte der 90er Jahre steht mit der SRS dieses besonders gut geeignete Untersuchungsverfahren zur Verfügung. Hierbei wird ein schwach radioaktiver Stoff (in aller Regel Octreoscan ) in die Armvene injiziert und nach einer Einwirkzeit von 4 bis 24 Stunden lagert sich dieser Stoff an den Zellen des neuroendokrinen Tumors an. Es dockt dabei an den unten abgebildeten Rezeptor für Somatostatin (SMS) an.

Abbildung 1: Schematische Darstellung des SMS-Rezeptor (nach Reisine, Bell 1995)
Somatostatin-Rezeptor-Szintigraphie (SRS)
Nach der Einwirkzeit von 4 bzw. 24 Stunden werden mit einer sogenannten Gamma-Kamera Bilder des Gesamtkörpers von vorn (anterior) und hinten (posterior) aufgenommen. Die Liegezeit in der abgebildeten Gamma-Kamera (Siemens, Erlangen, Deutschland) beträgt insgesamt ca. 1,5 Stunden verteilt auf mehrere Abschnitte.

Abbildung 2: Gamma-Kamera der Firma Siemens ©
Die so erhobenen Bild-Daten lassen sich wie folgt darstellen: man erkennt die Kontur eines menschlichen Körpers mit intensiver Speicherung der Radioaktivität (schwarz) im Bereich der Leber, der Milz, der Nieren sowie des Darmes. Im gezeigten Beispiel erkennt man als krankhafte Veränderung die Speicherung in der Mitte des Bauchraums, die einem neuroendokrinen Tumor des Dünndarms entspricht.

Abbildung 3: Ganzkörper-Szintigraphie mittels Octreoscan ©
Mit Hilfe dieses Verfahrens lassen sich gezielt alle neuroendokrinen Tumor-Orte darstellen, d.h. es ist ein wichtiges Instrument zum Auffinden von einem Primärherd einer neuroendokrinen Neoplasie, aber auch aller womöglich vorhandener Metastasen (Tochtergeschwülste); immer voraussetzend, dass dieser Tumor auch den Somatostatin-Rezeptor aufweist.
Positronen-Emissions-Tomographie (PET)
Als neuere Weiterentwicklung der Diagnostik neuroendokriner Tumoren ist die Positronen-Emissions-Tomographie (PET) zu nennen, bei der ebenfalls mit Hilfe radioaktiver Stoffe Ganzkörperuntersuchungen durchgeführt werden. Dort gibt es neben der Möglichkeit über den bekannten Somatostatin-Rezeptor (das wäre z.B. das 68Gallium-DOTATOC/DOTATATE-PET) zu untersuchen eine weitere Möglichkeit. Mit Hilfe des Stoffwechsels der diversen Hormone, die neuroendokrine Zellen umsetzen, gelingt es dem Stoff DOPA mit dem radioaktiven Fluor-Atom 18F speziell in diese Zellen aufgenommen zu werden, so dass man von außen mit dem unten abgebildeten PET-CT-Gerät dreidimensionale Bilder des Körpers aufnehmen kann.
Schlechter differenzierte NEN wie NEC weisen einen erhöhten Glucose-Stoffwechsel auf und sind so mittels FDG (Fluorodesoxyglucose) gut darstellbar.

Abbildung 4: PET-CT der Firma Siemens ©
© ENETS-Zentrums Marburg